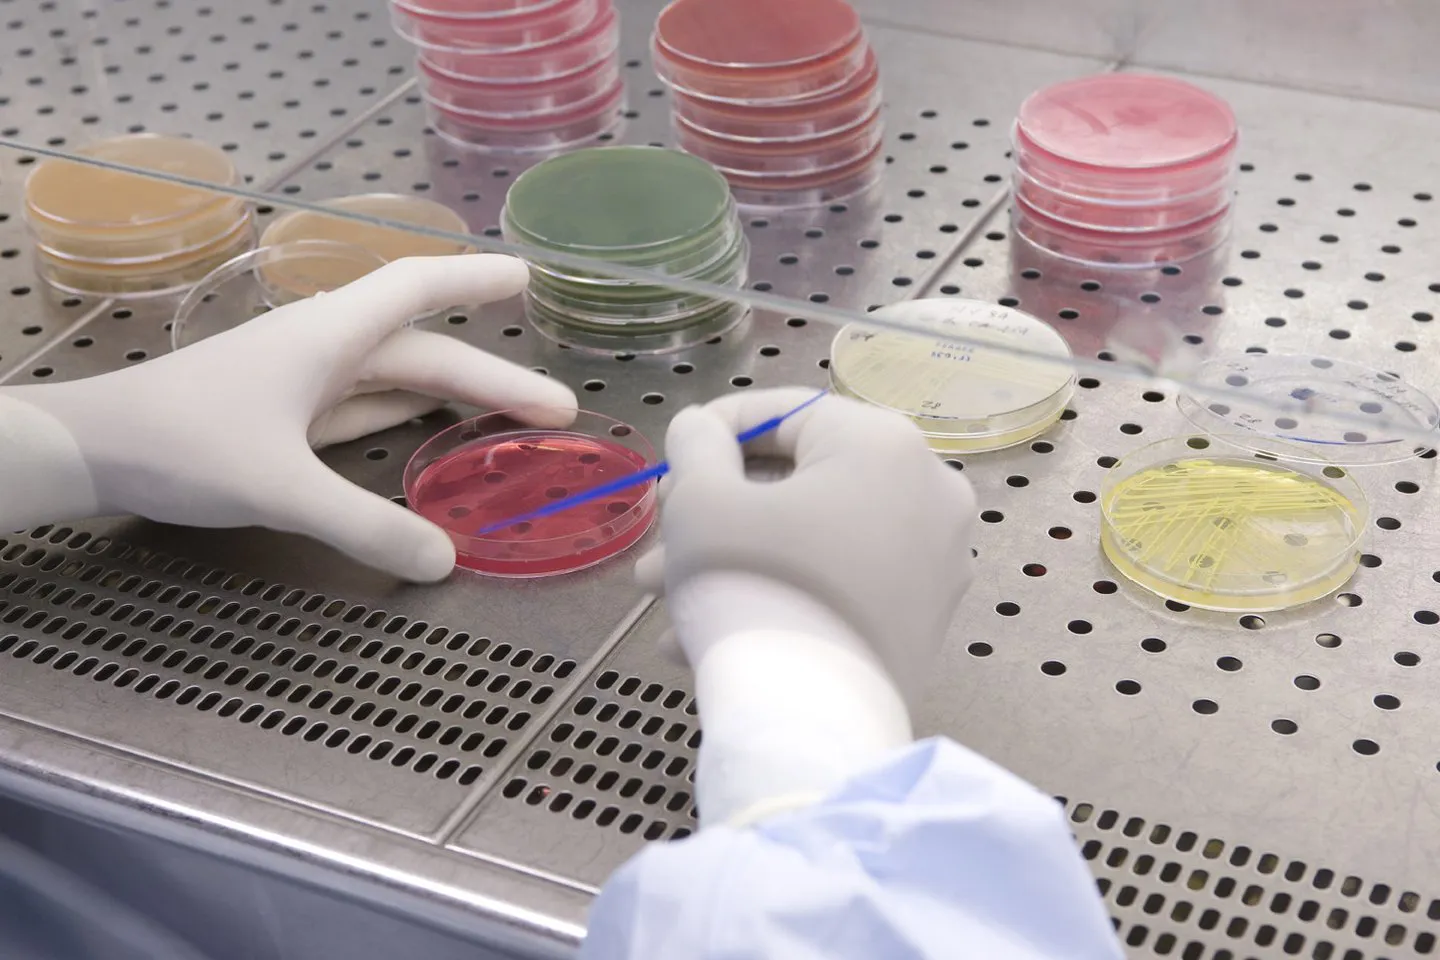

Ankona
Zakład w Ankonie
Zakład w Ankonie, zlokalizowany zaledwie kilka kilometrów od jednego z najważniejszych portów na Adriatyku, specjalizuje się w produktach medycznych eksportowanych do 67 krajów.
Uzyskał potwierdzenie zgodności z unijną GMP i może także produkować środki farmaceutyczne o dużej aktywności, takie jak hormony oraz antybiotyki z grup innych niż beta-laktamy i cefalosporyny. Ministerstwo Zdrowia wydało także zgodę na produkcję w zakładzie materiałów medycznych i chirurgicznych oraz na wykorzystanie środków odurzających i psychotropowych w produkcji leków. Zakład może także produkować wyroby medyczne.
Podstawowym przedmiotem działalności zakładu jest produkcja stałych postaci leków, ale ważnym elementem są też płyny niesterylne oraz półstałe postaci leków. Specjalny dział spółki koncentruje się na produkcji niewielkich serii produktów farmaceutycznych na potrzeby badań klinicznych, także dla podmiotów trzecich.
Zakład dysponuje szeregiem certyfikatów wydanych przez TÜV SÜD w Monachium: UNI EN ISO 9001:2015 – System Jakości; UNI EN ISO 13485:2016 – System Zarządzania Jakością; UNI EN ISO 14001:2015 – Środowisko oraz BS OHSAS 18001:2007 – Bezpieczeństwo.
W zakładzie wdrożono zaawansowany projekt oszczędzania energii. Ten nagradzany system został opracowany w celu ograniczenia zużycia energii, przy jednoczesnym utrzymaniu parametrów wymaganych zgodnie z GMP. Wykorzystuje on sprzyjające warunki klimatyczne na zewnątrz (niższy punkt rosy) w celu podwyższenia temperatury wody lodowej stosowanej do kontroli klimatu wewnątrz budynku. Udało się dzięki temu ograniczyć zużycie energii o około 830 MWh rocznie, co przekłada się na roczną oszczędność ok. 10 000m3 wody dostarczanej przez zakład użyteczności publicznej do użytku domowego (woda pitna).
Z całkowitej powierzchni wynoszącej 177 000 m2 ponad 15 000 m2 stanowią pomieszczenia produkcyjne, 660 m2 przeznaczono na wytwarzanie eksperymentalnych produktów farmaceutycznych, 3 500 m2 zajmują laboratoria, 5 000 m2 to pomieszczenia do składowania surowców i opakowań, 21 700 m2 zarezerwowano na magazynowanie na potrzeby dystrybucji, a 22 000 m2 zajmuje przestrzeń i systemy biurowe.